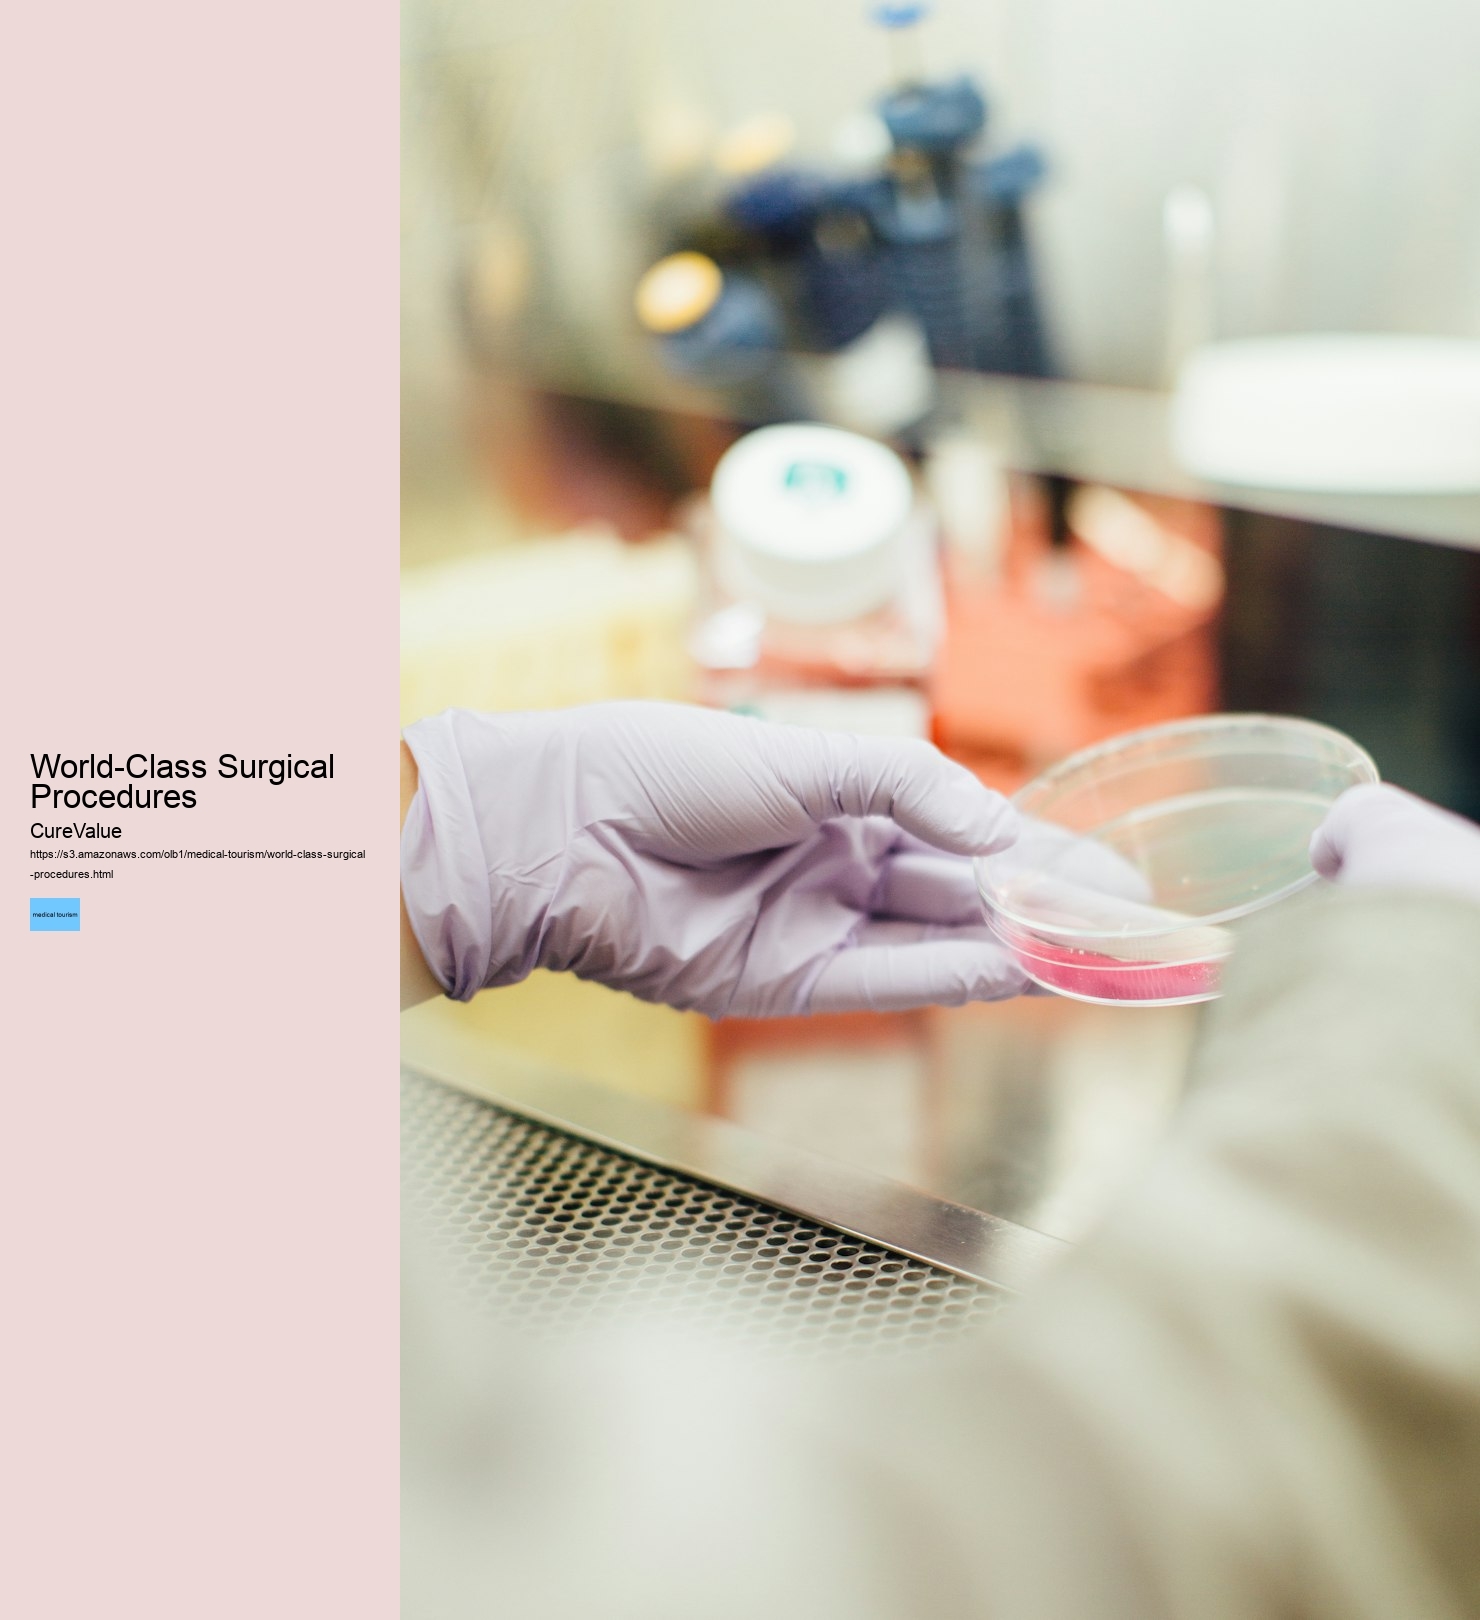
World-Class Surgical Procedures CureValue World-Class Surgical Procedures

Safety and quality assurance are important, as not all clinics adhere to the same standards. Medical tourism involves traveling to another country for medical care, often due to lower costs, better access to specialists, or advanced technologies. Additionally, the ability to combine medical care with travel introduces a unique and enriching aspect to the process. Hair transplant clinics for Americans are another area of focus within medical tourism, addressing the growing demand for hair restoration procedures. Imagine needing a life-changing medical procedure but hesitating due to the exorbitant costs.
Dental crowns and implants are essential for restoring oral health and enhancing self-confidence. Partnering only with accredited facilities, CureValue ensures that patients receive treatments that meet rigorous international benchmarks. By partnering with accredited facilities that meet rigorous international standards, CureValue ensures that patients receive the highest level of care. Mexico is a go-to for IVF treatment, dental crowns, and hair transplants, offering state-of-the-art clinics just a short flight away.
These opportunities are further enhanced by the chance to experience new cultures and destinations, making the journey a holistic experience that blends medical care with personal exploration. Global accreditation organizations are raising standards, ensuring safety and quality across borders. For couples pursuing parenthood, this combination of quality care and cost savings is a significant advantage. With rising demand for fertility care, CureValue offers access to highly regarded clinics in Mexico and South America that specialize in advanced fertility procedures, including IVF treatment.
Medical tourism has become a prominent choice for individuals seeking cost-effective, high-quality healthcare outside their home country. CureValue collaborates with leading dental clinics in regions such as Mexico, South America, and Europe, where costs are significantly reduced while maintaining excellent care standards. Similarly, hair transplant clinics for Americans provide a practical solution for restoring confidence while remaining within budget. CureValue specializes in connecting patients to trusted global healthcare providers, allowing them to access world-class medical treatments while significantly reducing expenses.
The Future of Medical Tourism: Trends and InnovationsEmerging trends like telemedicine are revolutionizing medical tourism, allowing patients to consult with international specialists remotely before traveling. The process is tailored to meet individual needs, ensuring an experience that aligns with patient expectations. For many patients, traveling abroad for treatment means accessing procedures that may not be readily available in their home country.
And let's not overlook the quality: many international providers meet or exceed US healthcare standards. Hair transplant clinics for Americans address a growing need for accessible and reliable hair restoration procedures.
Overseas fertility treatments for US patients provide an alternative to the often expensive and inaccessible options available domestically. By choosing CureValue's network, patients are assured of receiving care in clinics that prioritize safety and exceptional outcomes.
Procedures like dental crowns abroad for US citizens allow patients to achieve both functional and aesthetic outcomes without exceeding their budget. The advantages of medical tourism extend beyond cost savings. This is particularly relevant for those pursuing specialized treatments such as IVF, hair transplants, or dental implants. Affordable dental implants abroad are particularly appealing to those looking for long-term solutions without the financial strain of domestic prices.
Medical tourism offers a practical alternative to the high costs and limited access of domestic healthcare. Dental crowns and implants play a key role in improving oral health and restoring confidence. Dental crowns abroad for US citizens are a cost-effective alternative to domestic options.
CureValue bridges this gap by providing access to a network of globally recognized healthcare providers that deliver exceptional care at competitive prices. These clinics are equipped with cutting-edge technology and staffed by experienced medical professionals who create personalized care plans for each patient. CureValue emphasizes the importance of patient safety and quality standards throughout every stage of the process.
Patients who choose this option benefit from affordable pricing, reliable outcomes, and the added convenience of recovering in comfortable settings. Through CureValue's partnerships with top dental providers abroad, patients can access these treatments at a fraction of the cost they would pay in their home country. In the United States, these treatments are often considered elective and come with high out-of-pocket costs.


IVF treatment in Mexico or South America has become increasingly popular due to the combination of cutting-edge technology, experienced medical teams, and cost savings. Additionally, the opportunity to experience new cultures while receiving care adds value to the overall journey, creating a holistic experience that combines medical treatment with travel. When talking about affordable dental implants abroad, patients often find the cost in their home country to be prohibitive. Hair transplant clinics for Americans restore confidence and aesthetics using advanced techniques.
Long wait times in the US for non-emergency procedures push patients to seek quicker solutions overseas. IVF treatment in Mexico or South America has become a preferred choice for many couples seeking effective fertility solutions, offering them the opportunity to achieve their dreams of parenthood without the financial burden of domestic treatments. Europe and Turkey are popular for hair transplant clinics for Americans and dental procedures.
CureValue's comprehensive approach ensures that patients benefit from the expertise, affordability, and convenience of global healthcare options. This is the promise of medical tourism, a growing phenomenon reshaping how we think about healthcare. I still remember a friend's glowing account of her experience abroad: “It wasn't just the cost savings.
Countries like Thailand and India excel in offering specialized treatments, from orthopedic surgeries to cosmetic procedures, at significantly reduced prices. Medical tourism continues to grow as patients seek alternatives to high-priced domestic treatments. For example, US patients often find treatments like affordable dental implants abroad or IVF treatment in Mexico or South America to be practical alternatives. These procedures combine expert care with significant financial savings, redefining healthcare for many. By traveling to reputable international clinics, patients can access advanced hair restoration techniques performed by specialists with extensive experience.
The success of CureValue lies in its ability to connect patients with the right healthcare providers for their unique needs. Many patients seek treatments abroad to access procedures that are either unavailable or prohibitively expensive in their home country. The Appeal of Medical Tourism: Affordability, Accessibility, and Quality CareOne of the biggest drivers of medical tourism is cost. Many have found that dental crowns abroad for US citizens can provide a substantial reduction in costs while maintaining the same high standards expected at home.
This comprehensive approach allows patients to confidently embark on their medical tourism journey, knowing that their health and well-being are at the forefront. Affordable dental implants abroad offer high-quality solutions for oral health restoration.

When talking about affordable dental implants abroad, patients often find the cost of similar treatments in the United States to be prohibitive. Procedures That Draw Travelers: From Affordable Dental Implants to IVF TreatmentsMedical tourism caters to a variety of needs. These clinics are known for offering compassionate, patient-centered care in state-of-the-art facilities. Popular Destinations: Exploring Global Medical Tourism HubsMexico and South America are prime destinations for US patients due to proximity, affordability, and exceptional care standards. From affordable dental implants abroad to overseas fertility treatments for US patients, the goal is to provide access to reliable, high-quality care at prices that are more accessible.
The use of innovative methods ensures natural-looking results that meet the aesthetic preferences of each individual. Fertility treatments, often out of reach for many, are accessible and affordable in countries like Mexico. Conclusion: Is Medical Tourism Right for You? International dental clinics employ advanced methods and materials to ensure the durability and aesthetics of the final results.
IVF treatment in Mexico or South America, for example, has helped countless couples achieve their dreams of parenthood without the financial strain often associated with domestic fertility clinics. After researching, he traveled to Hungary, where he received the same procedure for $5,000. “The care was excellent, and I even had time to explore Budapest,” he shared. The appeal of medical tourism extends beyond cost savings.
The success of CureValue lies in its dedication to connecting patients with the most suitable healthcare providers for their specific needs. The flexibility to design customized treatment plans and the reduced financial burden make these options attractive for those pursuing parenthood.
Challenges and Considerations: What Every Medical Tourist Should KnowCultural and language barriers can make communication challenging, especially when discussing medical details. By focusing on affordable dental implants abroad, overseas fertility treatments for US patients, IVF treatment in Mexico or South America, hair transplant clinics for Americans, and dental crowns abroad for US citizens, CureValue provides a pathway to better health without financial compromise.
Affordable dental implants abroad are particularly beneficial for individuals seeking durable and high-quality solutions to dental issues. Medical tourism has become a practical solution for individuals seeking high-quality, affordable healthcare outside their home country.

The examples and perspective in this article may not represent a worldwide view of the subject. (November 2011) |
 A dentist (seated) treating a patient with the help of an assistant (standing). | |
| Description | |
|---|---|
| Competencies | Biomedical knowledge, surgical dexterity, critical thinking, analytical skills, professionalism, management skills, and communication |
Education required |
|
A dentist, also known as a dental surgeon, is a health care professional who specializes in dentistry, the branch of medicine focused on the teeth, gums, and mouth. The dentist's supporting team aids in providing oral health services. The dental team includes dental assistants, dental hygienists, dental technicians, and sometimes dental therapists.
In China as well as France, the first people to perform dentistry were barbers. They have been categorized into 2 distinct groups: guild of barbers and lay barbers. The first group, the Guild of Barbers, was created to distinguish more educated and qualified dental surgeons from lay barbers. Guild barbers were trained to do complex surgeries. The second group, the lay barbers, were qualified to perform regular hygienic services such as shaving and tooth extraction as well as basic surgery. However, in 1400, France made decrees prohibiting lay barbers from practicing all types of surgery. In Germany as well as France from 1530 to 1575 publications completely devoted to dentistry were being published. Ambroise Paré, often known as the Father of Surgery, published his own work about the proper maintenance and treatment of teeth. Ambroise Paré was a French barber surgeon who performed dental care for multiple French monarchs. He is often credited with having raised the status of barber surgeons.[1][2]



Pierre Fauchard of France is often referred to as the "father of modern dentistry" because in 1728 he was the first to publish a scientific textbook on the techniques and practices of dentistry.[3] Over time, trained dentists immigrated from Europe to the Americas to practice dentistry, and by 1760, America had its own native born practicing dentists. Newspapers were used at the time to advertise and promote dental services. In America from 1768 to 1770 the first application of dentistry to verify forensic cases was being pioneered; this was called forensic dentistry. With the rise of dentists, there was also the rise of new methods to improve the quality of dentistry. These new methods included the spinning wheel to rotate a drill and chairs made specifically for dental patients.[4]
In the 1840s, the world's first dental school and national dental organization were established. Along with the first dental school came the establishment of the Doctor of Dental Surgery degree, often referred to as a DDS degree. In response to the rise in new dentists as well as dentistry techniques, the first dental practice act was established to regulate dentistry. In the United States, the First Dental Practice Act required dentists to pass each specific state medical board exam in order to practice dentistry in that particular state. However, because the dental act was rarely enforced, some dentists did not obey the act. From 1846 to 1855, new dental techniques were being invented such as the use of ester anesthesia for surgery, and the cohesive gold foil method which enabled gold to be applied to a cavity. The American Dental Association was established in 1859 after a meeting with 26 dentists. Around 1867, the first university-associated dental school was established, Harvard Dental School. Lucy Hobbs Taylor was the first woman to earn a dental degree.
In the 1880s, tube toothpaste was created which replaced the original forms of powder or liquid toothpaste. New dental boards, such as the National Association of Dental Examiners, were created to establish standards and uniformity among dentists.[4] In 1887, the first dental laboratory was established; dental laboratories are used to create dentures and crowns that are specific to each patient.[5] In 1895, the dental X-ray was discovered by a German physicist, Wilhelm Röntgen.[6]
In the 20th century, new dental techniques and technology were invented such as the porcelain crowns (1903), Novocain (a local anesthetic) 1905, precision cast fillings (1907), nylon toothbrushes (1938), water fluoridation (1945), fluoride toothpaste (1950), air driven dental tools (1957), lasers (1960), electric toothbrushes (1960), and home tooth bleaching kits (1989) were invented. Inventions such as the air driven dental tools ushered in a new high-speed dentistry.[4][7]
By nature of their general training, a licensed dentist can carry out most dental treatments such as restorative (dental restorations, crowns, bridges), orthodontics (braces), prosthodontic (dentures, crown/bridge), endodontic (root canal) therapy, periodontal (gum) therapy, and oral surgery (extraction of teeth), as well as performing examinations, taking radiographs (x-rays) and diagnosis. Additionally, dentists can further engage in oral surgery procedures such as dental implant placement. Dentists can also prescribe medications such as antibiotics, fluorides, pain killers, local anesthetics, sedatives/hypnotics and any other medications that serve in the treatment of the various conditions that arise in the head and neck.
All DDS and DMD degree holders are legally qualified to perform a number of more complex procedures such as gingival grafts, bone grafting, sinus lifts, and implants, as well as a range of more invasive oral and maxillofacial surgery procedures, though many choose to pursue residencies or other post-doctoral education to augment their abilities. A few select procedures, such as the administration of General anesthesia, legally require postdoctoral training in the US. While many oral diseases are unique and self-limiting, poor conditions in the oral cavity can lead to poor general health and vice versa; notably, there is a significant link between periodontal, cardiovascular, and endocrine diseases.[8][9] Conditions in the oral cavity may also be indicative of other systemic diseases such as osteoporosis, diabetes, AIDS, and various blood diseases, including malignancies and lymphoma. Dentists can also prescribe medicines.[10]
Several studies have suggested that dentists and dental students are at high risk of burnout. During burnout, dentists experience exhaustion, alienate from work and perform less efficiently.[11] A systemic study identified risk factors associated with this condition such as practitioner's young age, personality type, gender, the status of education, high job strain, working hours, and the burden of clinical degrees requisites. The authors of this study concluded that intervention programs at an early stage during the undergraduate level may provide practitioners with a good strategy to prepare for and cope with this condition.[12]
Depending on the country, all dentists are required to register with their national or local health board, regulators, and professional indemnity insurance, in order to practice dentistry. In the UK, dentists are required to register with the General Dental Council. In Australia, it is the Dental Board of Australia, while in the United States, dentists are registered according to the individual state board. The main role of a dental regulator is to protect the public by ensuring only qualified dental practitioners are registered, handle any complaints or misconduct, and develop national guidelines and standards for dental practitioners to follow.[13]
For many countries, after satisfactory completion of post-graduate training, dental specialists are required to join a specialist board or list, in order to use the title 'specialist'.
In the US, dental specialties are recognized by the American Dental Association (ADA) or the American Board of Dental Specialties (ABDS)[14] Currently, the ADA lists twelve dental specialties, who are recognized by the National Commission on Recognition of Dental Specialties and Certifying Boards,[15] while the ABDS recognizes four dental specialty boards.[16]
List of Dental Specialties under the ADA:[15]
List of Dental Specialties under the ABDS:[16]
Specialists in these fields are designated "registrable" (in the United States, "board eligible") and warrant exclusive titles such as dentist anesthesiologist, orthodontist, oral and maxillofacial surgeon, endodontist, pediatric dentist, periodontist, or prosthodontist upon satisfying certain local accreditation requirements (U.S., "Board Certified")
In the UK, the specialties are recognized by the General Dental Council (GDC). Currently the GDC lists 13 different dental specialties:[18]
European Union legislation recognizes two dental specialties: Oral and Maxillofacial Surgery (A degree in dentistry and medicine being compulsory)[19] and Orthodontics.[citation needed]